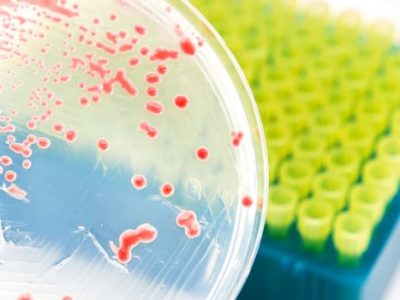
Patogenos alimentarios

Elikadura-gaixotasunekiko pertsona kalteberak
Adinekoek, haurrek, haurdunek eta immunodeprimituek arrisku handiagoa dute elikagaiek transmititutako gaixotasunen bat izateko edo ondorio larriagoak
Elikagaien Alerta: Listeria monocytogenes saltxitxetan
Italiatik etorritako saltxitxa batzuetan Listeria monocytogenes zegoela ohartarazi...
Elikagaien Alerta: A hepatitisaren birusa basoko fruta izoztuetan
Belgikatik datozen zenbait produktu izoztuetan A hepatitisaren birusa antzeman da...
Alertaren Eguneratzea: Onddo frijituak oliba-oliotan (Boletus edulis) – Toxina estafilokozikoa
Euskal Autonomia Erkidegoko osasun-agintariek, Informazioa Azkar Trukatzeko Sistema Koordinatuaren (SCIRI) bidez...
Sasoiko errezeta: Udako entsalada erraza
Orain entsalada erraz eta osasungarri bat prestatu ahal izango duzu sasoiko elikagaiekin
Elikagaien Alerta eguneratua: Häagen-Dazs markako banilla-izozkietan
Frantziako osasun-agintariek jakinarazi dute, etileno oxidoa dagoela...
Zer dira itsas biotoxinak?
Itsas biotoxinak zenbait itsas mikroorganismok, eskuarki algek, sortzen dituzten toxinak dira. Alga horien hazkunde handia dagoenean
Zein da pertsona baten nutrizio-egoera optimoa?
Nutrizioak pertsona edo kolektibo batengan sortzen duen osasuna eta ongizatea da nutrizio‑egoera. Pertsonok “nutrizio-beharrak” ditugu, gure
Elikagaien patogeno nagusiak
Patogenoak gaixotasunak sor ditzaketen eragileak dira (birusak, bakterioak edo beste batzuk). Hainbat patogeno elikagaien bidez transmititzen
Elikagaien gehigarriak: Jakin beharreko guztia
Elikagai gehigarrien erabilera zorrotz araututa dago. Baimena lortzeko, Elikagaien Segurtasuneko Europako Agintaritzak (EFSA) aurretiaz ebaluatu behar